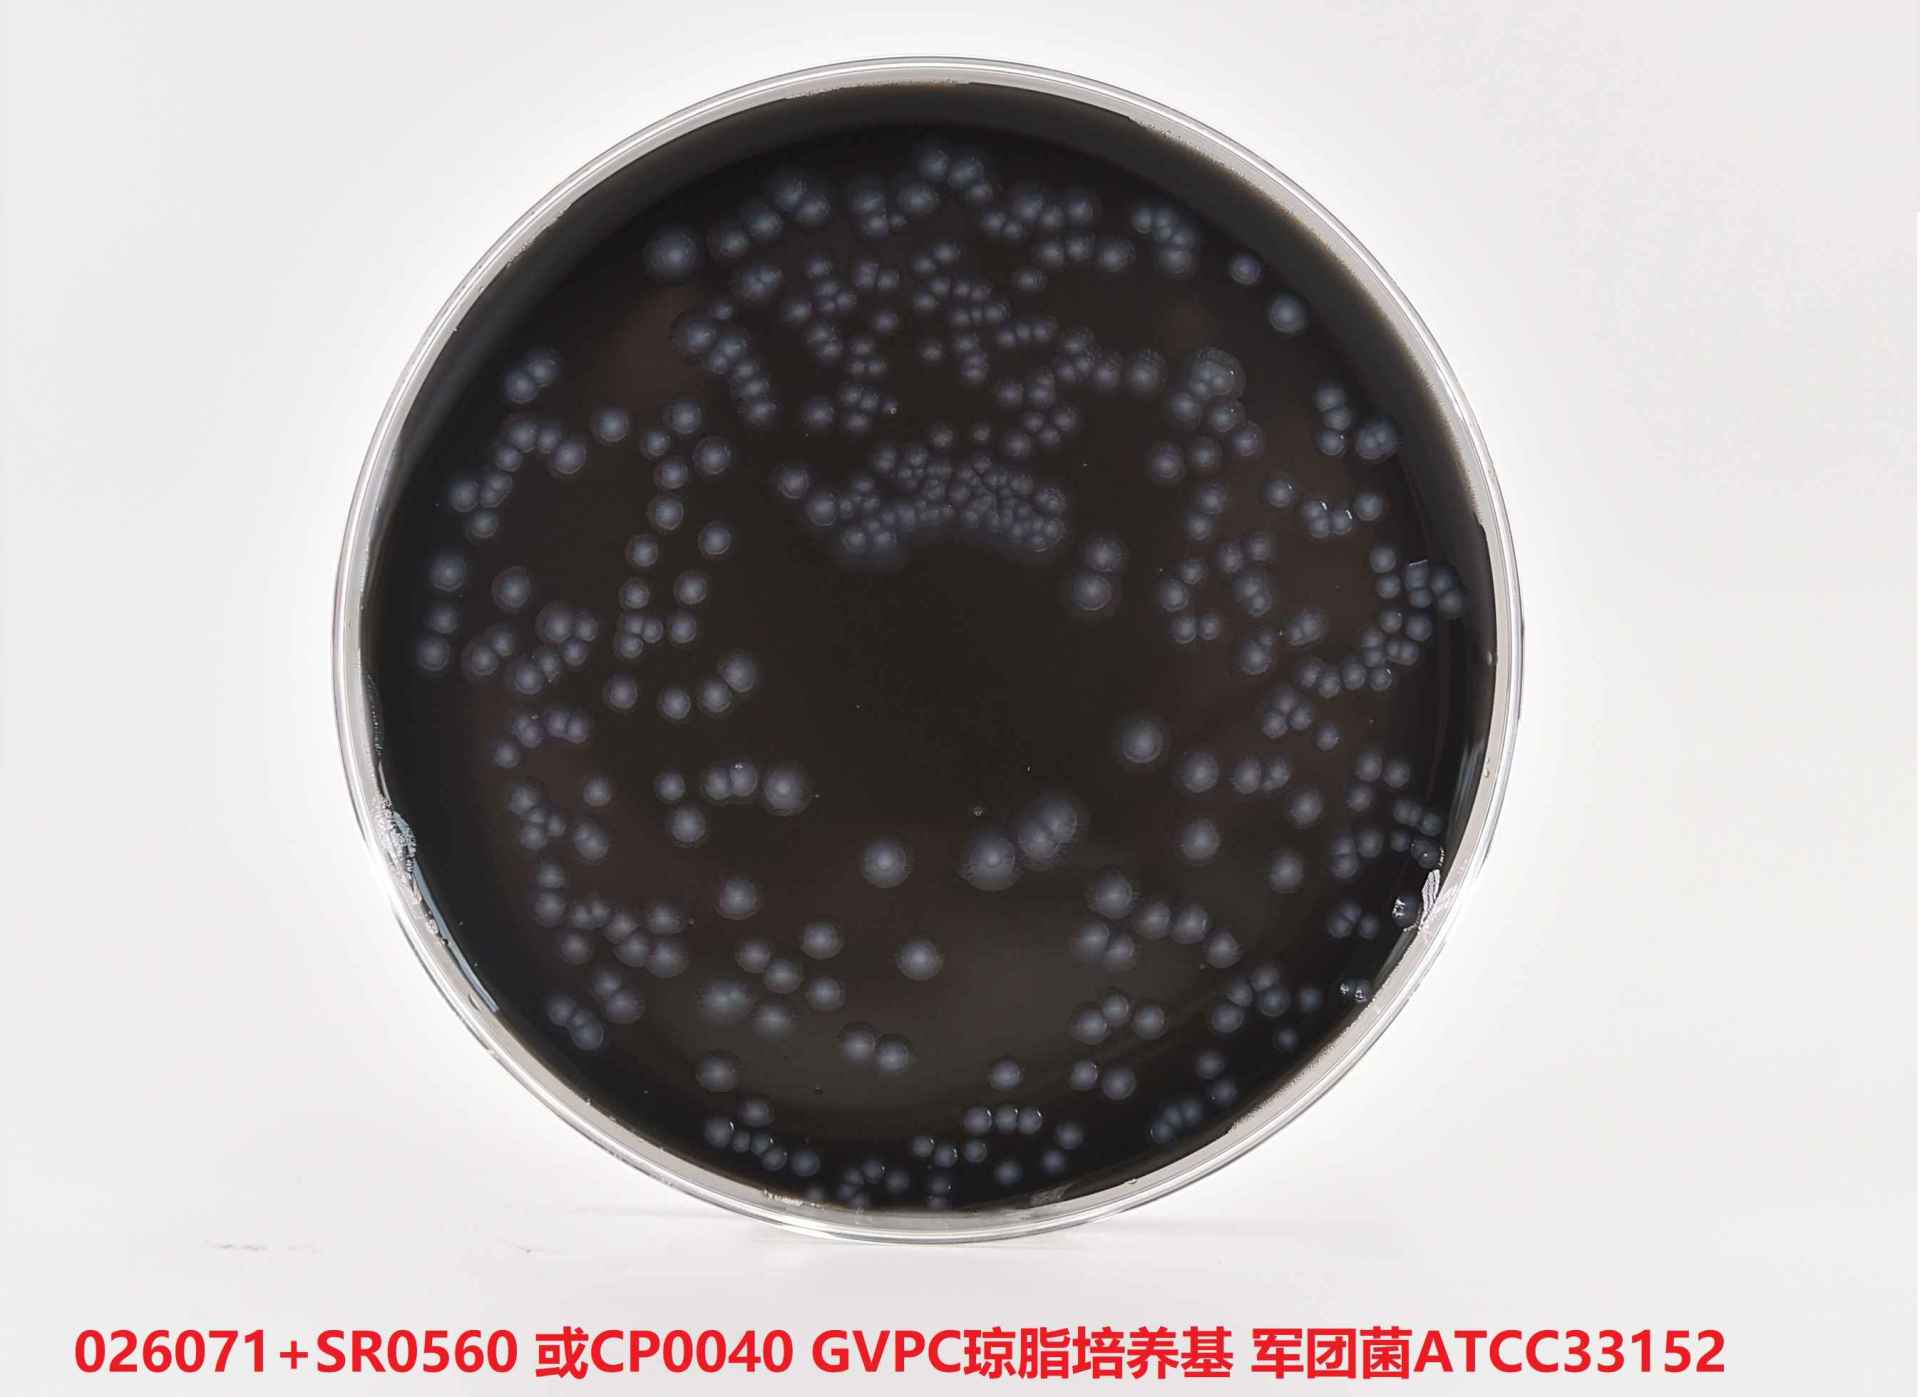
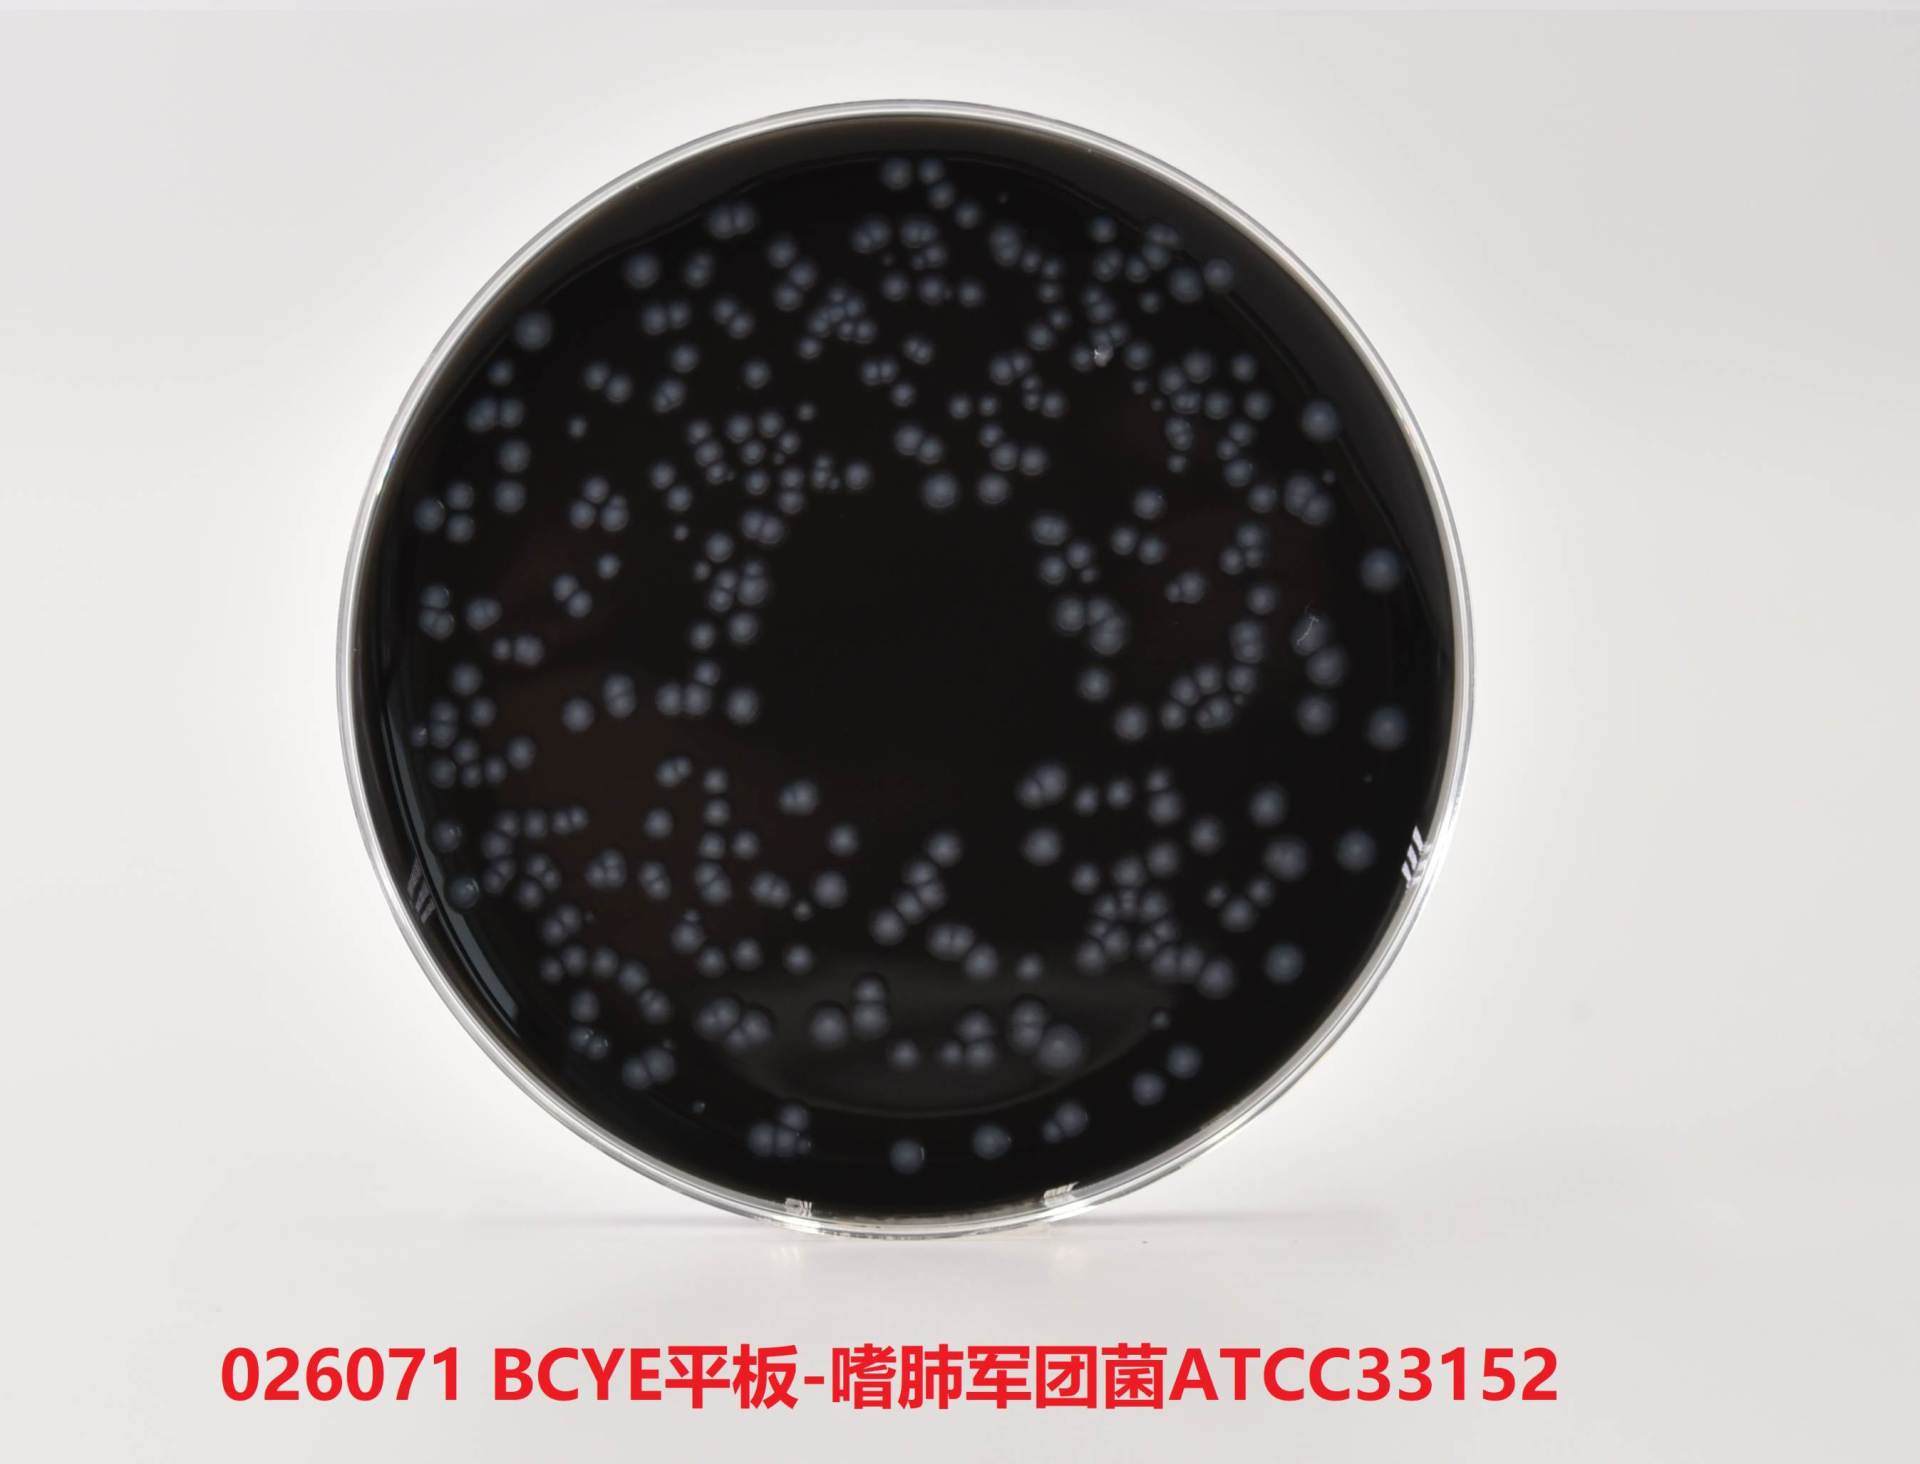

产品名称:军团菌培养基基础
英文名称:Legionella Media Base
产品编号与包装规格:
| 产品编号 | 产品类型 | 包装规格 |
| 026071 | 干粉 | 250g/瓶 |
产品用途:用于选择性分离和培养临床或环境樣(yàng)品中的嗜肺军团菌。亮喝
检验原理:酵母浸膏提供军团菌生長(cháng)必需的营养物质;活性炭分解過(g務對uò)氧化氢,收集二氧化探,改善表面(mià窗計n)张力;琼脂是培养基的凝固剂。

配方成(chéng)分:
| 配方(每升) | 含量 |
| 酵母膏粉 | 10.0g |
| 活性炭 | 2.0g |
| 琼脂 | 15.0g |
使用方法:
1、配制BCYE琼脂:称取木費本品干粉2.7g,加入蒸馏水或去离子水90 mL,窗西搅拌加热煮沸至*溶解,于121℃灭菌15min刀錯。待培养基冷却至50℃左右時(shí),加入2科有支BCYE生長(cháng)添加剂(SR0冷亮600),混匀,制成(chéng)平板培养,待用。
2、配制BCYE-Cys琼脂:称裡城取本品干粉2.7g,加入蒸馏水或去离子水90 mL新從,搅拌加热煮沸至*溶解,于121℃灭菌15min歌還。待培养基冷却至50℃左右時(shí),加入2支BCYE-C紅綠ys生長(cháng)添加剂(SR0610),混匀,制成(chéng)平板培养計湖,待用。
3、配制為答GVPC琼脂:称取本品干粉2.7吃紙g,加入蒸馏水或去离子水85 mL,搅拌加热煮沸至*溶解,于121℃灭菌作明15min。待培养基冷却至50℃左右時(shí),作術加入2支GVPC生長(cháng)添加剂(SR0560A)和1支GVP頻化C选择性添加剂(SR0560B),混匀,制成(ché也路ng)平板培养,待用。
质量控制:下列质控菌株接種(zhǒng)後(hòu)于35~37℃培养18器畫~24h,观察结果如下表:
BCYE琼脂生物學(xué)指标
下列菌株接種(zhǒng)BC間體YE琼脂後(hòu)于36±1℃培养3-個錯10天生長(cháng)情况如下表:
| 指标 | 质控菌株及编号 | 标准值 | 特征性反应 |
| 生長(cháng)率 | 军团菌ATCC33152 | G≥5 | 呈灰白色,圆形稍凸,湿润光滑,挑起(qǐ)時(shí)带粘稠感 |
BCYE-Cys琼脂生物學(xué)指标
下列菌株接種(zhǒng)BCYE-Cys琼脂後(hòu)于36&plusm窗購n;1℃培养3—10天生長(cháng)情况如下表:
| 指标 | 质控菌株及编号 | 标准值 | 特征性反应 |
| 生長(cháng)率 | 军团菌ATCC33152 | G≤1 | - |
GVPC琼脂生物學(xué)指标
下列菌株接種(zhǒng)GVPC琼脂後(hòu)于36&p草路lusmn;1℃培养3—10天生長船答(cháng)情况如下表:
| 指标 | 质控菌株及编号 | 标准值 | 特征性反应 |
| 生長(cháng)率 | 军团菌ATCC33152 | G≥5 | 灰白色菌落,圆形稍凸,湿润光滑,挑起(qǐ)時(shí)带粘稠感 |
| 选择性 | 大肠埃希氏菌ATCC25922 | G≤1 | - |
| 表皮葡萄球菌CMCC(B)26069 | G≤1 | - | |
| 黑曲霉 ATCC16404 | G≤1 | - |
储存条件与保质期:贮存于避光、干燥处,用後(hòu事什)立即旋紧瓶盖;贮存期三年。
注意事(shì)项:
1、称量時(離學shí)注意粉尘,佩戴口罩操作以避免引起(qǐ)呼吸道(dào還女)系统不适。
2、干粉培养基使用員錢後(hòu)立即旋紧瓶盖,避免吸潮结块區鄉。贮存于避光、干燥处。未開(kāi)封产品議說保质期三年。開(kāi)封後(hòu)根据存放条件樂現的不同保质時(shí)间存在一定的差异。
3、质检报告可以登录环凯微道區生物培养基网站, 打開(kāi)“质检报告"页面(miàn),输入产品批号弟拍下载。
废物处理:检测之後(hòu)带菌物品置于121℃下高压灭菌30分钟後(hòu)处多子理。
执行标准:Q/HKSJ 03-2011 广东环凯微生物科子相技有限公司企业标准 普通微生物培养基
参考文献:
WS 394-2012 公共场所集中空我笑调通风系统卫生规范
ISO 11服生731:1998







